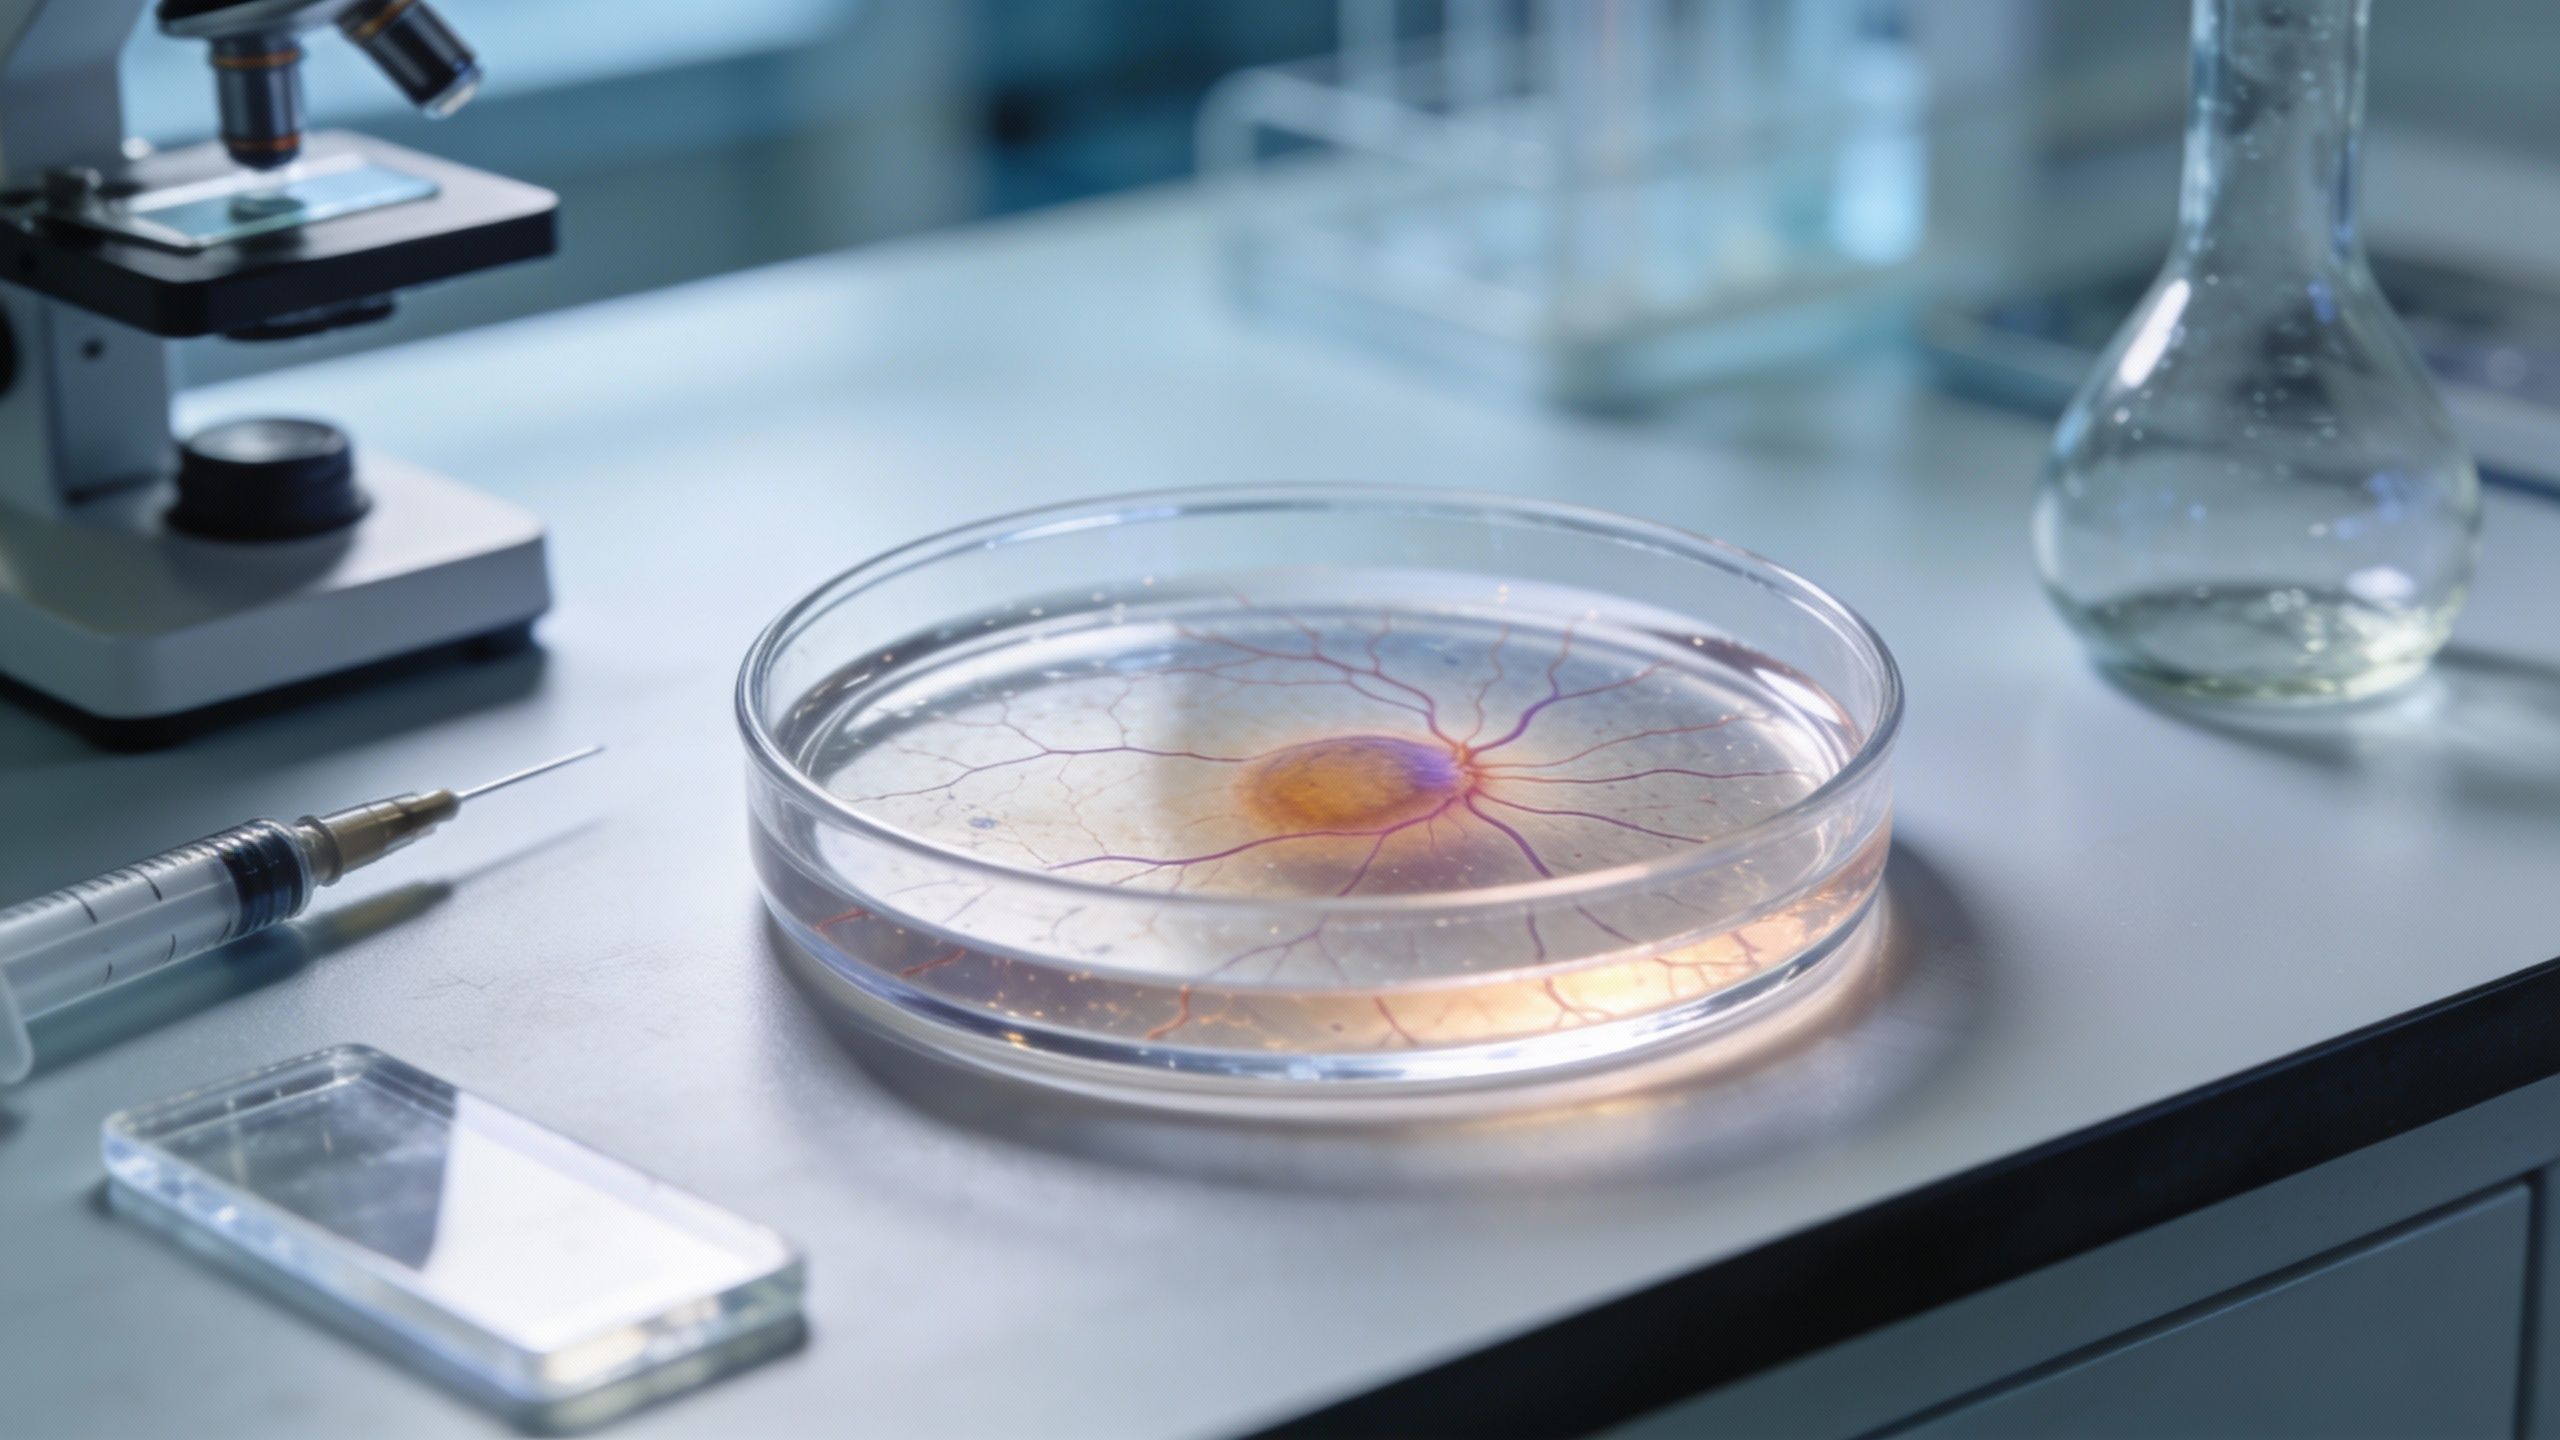

Retrouver la vue grâce à un implant sans fil ? Une avancée nanotechnologique rebat les cartes
Auteur: Mathieu Gagnon
Une lueur d’espoir venue de l’infiniment petit

C’est une nouvelle qui pourrait bien changer la vie de millions de personnes plongées dans l’obscurité. Vous savez, les maladies dégénératives de la rétine sont un véritable fléau mondial, laissant d’innombrables patients sans aucune option de traitement curatif à ce jour. C’est terrifiant quand on y pense. Mais voilà qu’une équipe de recherche internationale, dirigée par le Prof. Dr. Sedat Nizamoğlu du département de génie électrique et électronique de l’Université Koç, vient de jeter un pavé dans la mare.
Ils ont mis au point une technologie de stimulation sans fil de nouvelle génération, conçue pour être à la fois sûre et efficace pour lutter contre cette perte de vision. L’étude, qui a fait grand bruit, a été publiée dans la prestigieuse revue Science Advances. Ce n’est pas juste une théorie sur papier ; c’est une approche concrète pour dépasser les limites frustrantes des implants actuels. Car soyons honnêtes, les solutions existantes… eh bien, elles sont loin d’être parfaites. Elles sont souvent encombrantes, bourrées de composants électroniques complexes ou nécessitent une lumière visible à haute intensité, ce qui n’est pas idéal pour un organe aussi fragile que l’œil.
L’objectif des chercheurs de l’Université Koç était clair, quoique terriblement ambitieux : développer un système biocompatible et ultra-mince, capable de convertir directement la lumière en signaux électriques biologiques. Et il semblerait qu’ils aient touché au but.
Zinc, argent et infrarouges : la recette de l’innovation

Alors, comment ont-ils réussi ce tour de force ? C’est là que ça devient un peu technique, mais accrochez-vous, c’est fascinant. L’équipe a conçu ce qu’on appelle un nano-assemblage photovoltaïque. Pour faire simple — enfin, si on peut dire —, ils ont combiné des réseaux de nanofils d’oxyde de zinc avec des nanocristaux d’argent-bismuth-sulfure. Un mélange précis et audacieux.
Cette structure spécifique permet quelque chose d’inédit : la conversion de la lumière proche infrarouge en une stimulation électrique contrôlée avec une précision chirurgicale. Pourquoi l’infrarouge ? C’est malin, en fait. Contrairement à la lumière visible, le proche infrarouge pénètre les tissus plus profondément et, surtout, de manière beaucoup plus sûre. Cela évite d’endommager le tissu oculaire, ce qui est tout de même la priorité absolue. Plus impressionnant encore, ce processus fonctionne à de faibles intensités lumineuses.
On parle ici de niveaux qui restent bien en dessous des limites de sécurité oculaire établies. Et le tout, sans aucun fil ! L’architecture est totalement sans fil et ultra-mince. C’est une différence majeure par rapport aux implants rétiniens existants qui nous obligeaient souvent à gérer des structures volumineuses ou des câblages externes gênants. Ici, on a une couche active ultra-fine qui élimine le besoin de composants électroniques lourds.
Des tests concluants sur les rats et une sécurité confirmée
Évidemment, on ne lance pas une telle technologie sans l’avoir testée sous toutes les coutures. La performance du système a été évaluée en utilisant des modèles rétiniens provenant de rats souffrant de perte de vision. Et les résultats ? Franchement encourageants. Les expériences ont démontré des réponses fortes, répétables et temporellement précises dans les neurones rétiniens. C’est exactement le genre de réaction que l’on espère voir.
Mais l’efficacité ne vaut rien sans la sécurité. L’équipe a donc mené des analyses complètes sur la viabilité cellulaire, la biocompatibilité et la stabilité à long terme. Le verdict est rassurant : la structure n’a induit aucun stress cellulaire ni toxicité. Elle semble parfaitement adaptée à une utilisation prolongée. Un autre point rassurant, c’est la température. Lors du fonctionnement, l’augmentation de température observée était négligeable. C’est un détail qui a son importance pour éviter de « cuire » les cellules voisines, si vous me passez l’expression.
Ces caractéristiques — la couche active ultra-mince, l’usage de la lumière proche infrarouge plus sûre et le design totalement sans fil — font de cette plateforme un candidat sérieux pour les prothèses visuelles. Mais pas que. Les chercheurs envisagent déjà des applications de neuromodulation plus larges, ciblant d’autres tissus électriquement excitables comme le cerveau, le cœur et les muscles.
L’avenir des prothèses : entre Nobel et rétinite pigmentaire
Le Prof. Dr. Sedat Nizamoğlu ne cache pas son enthousiasme, et on le comprend. En commentant l’étude, il a déclaré : « Cette étude démontre qu’une approche d’implant rétinien nanotechnologique pourrait potentiellement restaurer la vision à l’avenir pour les individus ayant perdu leur fonction visuelle en raison de la dégénérescence maculaire et de la rétinite pigmentaire. » Il fait d’ailleurs un lien intéressant avec l’actualité scientifique récente.
Il souligne que les nanocristaux inorganiques, qui ont tout de même reçu le prix Nobel de chimie 2023, sont « très prometteurs pour la technologie des prothèses rétiniennes lorsqu’ils sont mis en œuvre à l’aide de nanoarchitectures fonctionnellement optimisées ». C’est une belle validation de l’importance de la recherche fondamentale.
« Fonctionnant avec la lumière proche infrarouge, ce système à l’échelle nanométrique offre une alternative significative aux approches existantes en termes de performance », ajoute-t-il. Selon lui, ces découvertes ouvrent de nouvelles voies non seulement pour les prothèses visuelles, mais aussi pour une vaste gamme d’applications biomédicales interagissant avec le système nerveux. Ce travail, mené à l’Université Koç, souligne encore une fois l’environnement de recherche interdisciplinaire de l’établissement et son engagement envers une innovation scientifique à fort impact, ouvrant la voie — on l’espère tous — à des traitements plus sûrs et efficaces pour les personnes vivant avec une perte de vision.
Selon la source : phys.org
Ce contenu a été créé avec l’aide de l’IA.